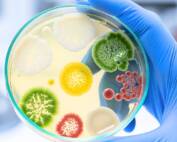
Biofilme

Produtos de Limpeza Profissionais e Sustentáveis
Papel Toalha para empresas
Papéis Toalha – Muitas opções e modelos para sua empresa!
Conheça as diversas possibilidades em papéis sanitários que temos em nossa linha de Fornecedor de Produtos de Limpeza . Sempre com foco na economia e bem-estar de seus funcionários e clientes.
Aqui você encontra os tradicionais tipos de papel interfolha e toalha bobina.
São vários níveis de maciez, resistência e gramaturas para diferentes tipos de exigência e níveis de sofisticação.
Fabricados no Brasil com mais alto perfil de qualidade e responsabilidade ambiental.
Temos toalhas de papel com o requinte e maciez da folha de papel toalha para empresa com folha dupla, papel toalha folha quadrupla ou tripla e até a folha de uma camada, que preza pela performance e economia. Tudo isso sem abrir mão da qualidade do nosso tradicional sistema de lhe atender com excelência.
Porta Papéis Toalha
São mais de 15 modelos, entre os tradicionais toalheiros com linhas retas da linha standard, até os mais modernos de linhas curvas. Altamente resistentes, conta com formas modernas, muita sofisticação, cores sólidas e mistas. Conte também com a linha Velada, onde a qualidade do material e a transparência vão te encantar!
Dispenser Papel Toalha Para Empresas
Papel Toalha e Dispensers – São fundamentais para o uso racional da toalha de papel e o mais importante, é que são desenvolvidos pela nossa indústria, de modo que a compatibilidade entre os papéis e os dispensers garanta a maior economia possível para sua empresa.
Você encontra todos os tipos e modelos de papéis toalha, papéis higiênicos, sabonetes e demais acessórios de alta performance, aqui na Hygibras.
Converse com nossos especialistas e escolha os melhores modelos para seu uso.
Toalheiros Sem Custo
Os dispensers para nossa linha de produtos, como o dispenser de papel, podem ser fornecido até mesmo sem custos adicionais. Converse com nossa equipe e descubra as vantagens desse sistema de comodato que provê os dispositivos e realiza as manutenções periódicas, sem custo para sua empresa.
A Hygibras seleciona os melhores papéis e dispensadores que funcionam em harmonia. Como são totalmente compatíveis, a economia e praticidade do sistema é ainda maior. Total aproveitamento em cada gota de sabonete e cada folha de papel.
Nossa linha é muito ampla e cobre todas as necessidades de produtos para os sanitários, ambulatórios, vestiários, entre outros ambientes.
Peça seus Produtos de Limpeza Profissional !
A Gente liga para Você!
Peça seus Produtos Diretamente ao Fornecedor de Produtos de Limpeza
A Gente liga para Você!
Papéis Toalha em Destaque
Papéis Toalha em Destaque

Linha de Papéis Sanitários Profissionais
Completa linha de produtos de higiene pessoal, como papel toalha, papéis higiênicos, que trazem o melhor da tecnologia, mantendo o toque de carinho e proteção que você merece de um fornecedor de papel toalha e papeis sanitários.
Exclusivas linhas Ultra, Premium e Basic que performam de acordo com a sua escolha.
Conheça a linha de papéis sanitários Optipaper em sua empresa e tenha o melhor do mercado para seus colaboradores.
Completa linha de produtos para Prevenção de Infecções Hospitalares & Limpeza Profissional, reconhecida por sua tradição e inovação desde 1955. Com capital e produção 100% brasileiros. Possui a rigorosa e respeitável certificação de qualidade do Manual de Boas Práticas da Anvisa e o selo verde ABNT PE-344 Ambiental para a linha Prax.
Produz grandes marcas de produtos de limpeza no mercado da América Latina em sua moderna planta na Grande São Paulo.
Linha Profissional de Toalhas de Papel
Possui uma linha completa de produtos de higiene pessoal, que trazem o melhor da tecnologia, sem deixar de lado o toque de carinho e proteção que você merece.
Completa linha de produtos para Prevenção de Infecções Hospitalares & Limpeza Profissional, reconhecida por sua tradição e inovação desde 1955. Possui a rigorosa e respeitável certificação de qualidade do Manual de Boas Práticas da Anvisa e selo verde ABNT PE-344
Clique Aqui e Conheça Nosso Guia Definitivo Sobre Produtos de Limpeza e Amplie Seus Conhecimentos!
Papel Higiênico em Destaque
Papel Higiênico em Destaque
Dispensers em Destaque
Dispensers em Destaque
Artigos Recentes sobre Produtos de Limpeza Profissional
Segurança do paciente: Como limpeza hospitalar evita infecções?
A segurança do paciente não se limita aos cuidados clínicos. As condições do ambiente [...]
Biofilme: o que é, como se forma e como eliminar na limpeza
Nem toda superfície que parece limpa está realmente livre de contaminação. Isso acontece por [...]
Fornecedor de produto de limpeza: o que avaliar ao escolher?
O fornecedor de produtos de limpeza tem influência direta na forma como a rotina [...]
Síndico profissional: como ele atua na economia de condomínios?
O síndico profissional atua com foco em organização e controle da rotina condominial, trazendo [...]
Artigos Muito Acessados – Produtos de Limpeza Profissionais
Os melhores produtos de limpeza profissional – Guia completo.
O que são produtos de limpeza profissionais? Produtos de limpeza profissionais constituem uma categoria essencial para a limpeza, desinfecção e higienização de ambientes domésticos e empresariais. Estes produtos são [...]
Papel Toalha Para Banheiro: Saiba como escolher!
O que é o papel toalha? Papel Toalha para Empresa ou Papel Toalha para Banheiro é um produto indispensável para todos os negócios, usados em grande quantidade principalmente em [...]
Artigos Recente sobre Produtos de Limpeza Profissional
Segurança do paciente: Como limpeza hospitalar evita infecções?
A segurança do paciente não se limita aos cuidados clínicos. As condições do ambiente hospitalar também influenciam esse cenário. [...]
Biofilme: o que é, como se forma e como eliminar na limpeza
Nem toda superfície que parece limpa está realmente livre de contaminação. Isso acontece por causa do biofilme, uma camada [...]
Fornecedor de produto de limpeza: o que avaliar ao escolher?
O fornecedor de produtos de limpeza tem influência direta na forma como a rotina da empresa funciona. Quando bem [...]
Síndico profissional: como ele atua na economia de condomínios?
O síndico profissional atua com foco em organização e controle da rotina condominial, trazendo mais clareza para decisões que [...]
Artigos mais Acessados
Os melhores produtos de limpeza profissional – Guia completo.
O que são produtos de limpeza profissionais? Produtos de limpeza profissionais constituem uma categoria essencial para a limpeza, desinfecção e higienização de ambientes domésticos e empresariais. Estes produtos são [...]
Papel Toalha Para Banheiro: Saiba como escolher!
O que é o papel toalha? Papel Toalha para Empresa ou Papel Toalha para Banheiro é um produto indispensável para todos os negócios, usados em grande quantidade principalmente em [...]
Sabonetes para Empresas em Destaque
Sabonetes para Empresas em Destaque
Depoimentos sobre nossos
Produtos de Limpeza
Gostei do papel folha dupla Optipaper, usava outra marca e gostei mais dessa.
Aqui na escola onde trabalho os dispensers e papéis são todos desta empresa, estou muito satisfeito com a qualidade destes produtos.
Técnicos muito educados e prestativos, mudei de endereço e precisava da troca de local dos dosadores e fui atendido rapidamente
Conheci essa distribuidora de produtos de limpeza através do google e recomendo a todos! Ótimo atendimento e produtos que dão resultado.
Estava gastando 3.000 folhas por semana aqui na minha empresa, graças a parceira com a hygibras os novos dispensers instalados em comodato me ajudaram e reduzir o meu consumo.
Técnicos muito atenciosos, alguns funcionários estavam com duvidas sobre a diluição e prontamente recebemos um treinamento para obter o melhor resultado
sempre compro o álcool em gel com hidratante, graças a ele as mãos não ficam mais secas
Gostei muito dos produtos, são de qualidade e preço justo!!!
Gosto muito dos dispensers, não deixam o gasto do papel ficar acima do necessário.
Panos Wipers em Destaque
Panos Wipers em Destaque
Segmentos em Produtos de Limpeza Profissional
Desinfetantes Profissionais em Destaque
Papel Toalha para Banheiro
Porta Papel Toalha para empresas e todos os produtos relacionados a higiene pessoal.
Suporte para papel higiênico, papéis toalha, papéis higiênicos, sabonete líquido, sabonete espuma e acessórios para sanitários.
Em nossa linha possuímos uma grande variedade de itens que nos conferem um destaque entre os Distribuidores de Produtos de Limpeza do Estado.
Papel Toalha Preço
Papel Toalha Para Empresas – Consulte nossos preços e produtos e surpreenda-se com os vários tipos e modelos. Desde detergentes, sanitizantes, desinfetantes de uso geral, desengraxantes, carrinho de limpeza, mop’s, desinfetantes hospitalares, ceras acrílicas, etc. Através de nosso atendimento consultivo de nosso Distribuidor de Produtos de Limpeza, selecionaremos os mais adequados produtos e acessórios para sua empresa.
Entre em contato e agende uma visita sem compromisso.